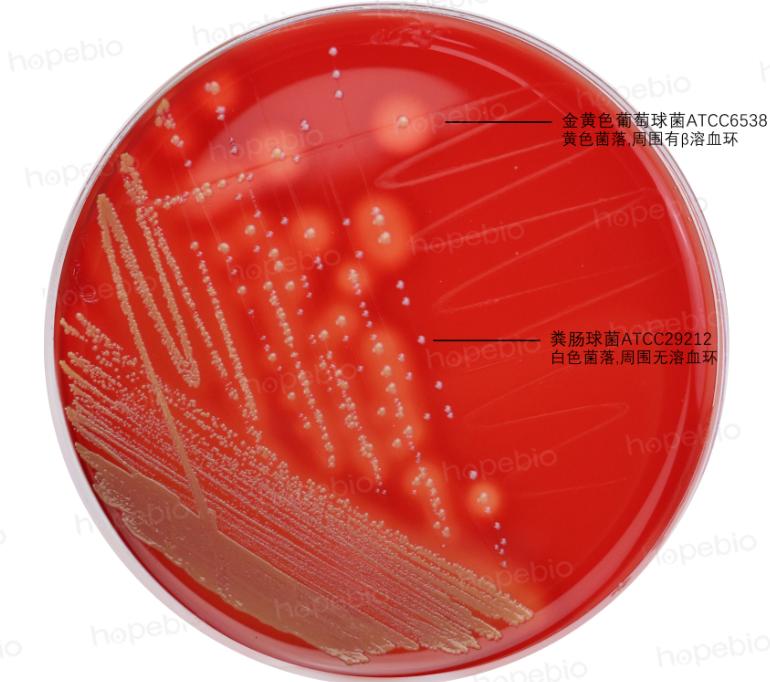
细菌溶血现象的原理,细菌革兰染色实验报告
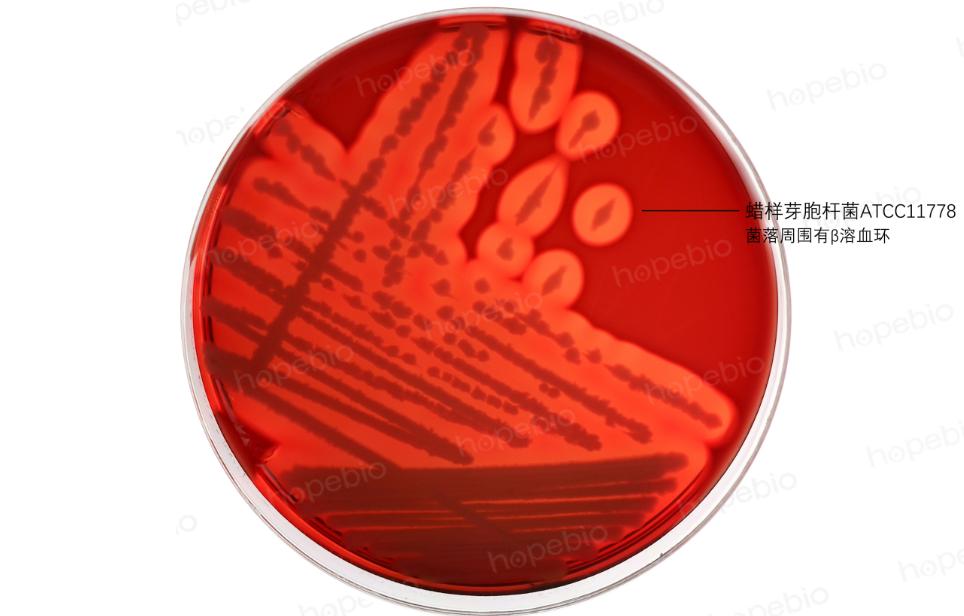
细菌溶血现象的原理,细菌革兰染色实验报告

一些细菌在生长过程中,可以产生溶血素,使红细胞破裂溶解,在血平板上生长时,菌落周围可观察到透明或半透明的溶血环,许多细菌的致病性都与溶血特性相关。由于不同细菌产生的溶血素不同,溶血能力也不相同,在血平板上的溶血现象也不相同,因此,溶血试验常用来进行细菌的鉴定。
(1)α溶血、β溶血和γ溶血
α溶血又称草绿色溶血,在菌落周围可观察到1~2mm的草绿色半透明溶血环,为高铁血红蛋白所致,α溶血环中的红细胞未完全溶解,是一种不完全溶血现象,常见的产生α溶血的菌株为肺炎链球菌、甲型溶血性链球菌。

图1 肺炎链球菌在血平板上的α溶血现象
β溶血又称为完全溶血,在菌落周围可观察到2~4mm界限分明、完全透明的溶血环。β溶血环中的红细胞完全溶解,是细菌产生的溶血素使红细胞完全溶解所致,许多致病性强的菌株都可形成β溶血,如乙型溶血性链球菌、金黄色葡萄球菌、霍乱弧菌等。γ溶血即不溶血,菌落周围无溶血现象。
注:制作溶血试验用的血平板,特别是金黄色葡萄球菌的溶血试验,通常选用脱纤维绵羊血。这是因为绵羊红细胞的细胞膜中的神经鞘磷脂含量较高,金黄色葡萄球菌产生的β溶血素作用于神经鞘磷脂裂解红细胞,试验中更易观察到溶血现象。
图2 金黄色葡萄球菌的β溶血和粪肠球菌的γ溶血
注:部分金黄色葡萄球菌不表现β溶血
图3 蜡样芽胞杆菌的β溶血
注:部分蜡样芽胞杆菌表现为α溶血

图4 产气荚膜梭菌的β溶血
注:产气荚膜梭菌有两种溶血素,能产生双溶血环,在β溶血环外围可隐约看到宽度约为3-5mm的不透明微弱溶血环
(2)李斯特氏菌溶血试验

图5 李斯特氏菌溶血试验
单增李斯特氏菌的溶血现象较弱,直接采用划线接种方法时在血平板上较难观察到溶血现象,因此在《GB4789.30-2016单核细胞增生李斯特氏菌检验》标准中,采用穿刺接种法可以更好的观察到李斯特氏菌的溶血现象,单增李斯特氏菌、斯氏李斯特氏菌、伊氏李斯特氏菌可观察到明显的β溶血环,英诺克李斯特氏菌无溶血。
(3)协同溶血试验(CAMP)
一些细菌能产生CAMP因子,可促进葡萄球菌的β-溶血素溶解红细胞的活性,因此在两菌的交界处溶血力增加,出现箭头状或半月状透明溶血区域。该试验常用于B群链球菌的鉴定,也用于单增李斯特氏菌的鉴定。
试验方法:挑取金黄色葡萄球菌ATCC25923在血平板上划平行直线,再挑取待测菌株垂直划线,距离金黄色葡萄球菌接种线约1mm但不要接触,置于36℃培养24-48h。
注:为何使用金黄色葡萄球菌ATCC25923做协同溶血试验,而不是任意一株金黄色葡萄球菌都能做?
金黄色葡萄球菌发生溶血主要靠四种溶血素:α、β、γ和δ。其中α、γ和δ溶血素又称为“打孔毒素”,在细胞膜上形成孔道,小分子和离子可以自由进出细胞,导致细胞代谢发生紊乱,最终发生裂解。而β溶血素的溶血机理不同,是通过水解细胞膜的鞘磷脂裂解细胞。多数金黄色葡萄球菌都有两种以上的溶血素基因高效表达,在血平板上可观察到完全透明的β溶血环,少数金黄色葡萄球菌只有β溶血素基因高效表达或无溶血素基因表达,在血平板上微弱溶血或不溶血。
金黄色葡萄球菌ATCC25923是一株表型不完全溶血的菌株,该菌主要产生β溶血素,在血平板上溶血现象非常微弱。B群链球菌可以产生一种CAMP蛋白(非酶蛋白),可以与β溶血素协同作用快速裂解红细胞,产生溶血现象。因此,在靠近金黄色葡萄球菌ATCC25923的B群链球菌周围可以观察到明显的溶血增强现象。而其他金黄色葡萄球菌若不产生β溶血素或本身产生多种溶血素形成了完全透明的β溶血,则无法发生协同溶血或无法观察到协同溶血现象。

图6 无乳链球菌(B群链球菌)协同溶血试验

图7 李斯特氏菌协同溶血试验
(4)神奈川现象
该试验是副溶血性弧菌特有的溶血现象,副溶血性弧菌在普通血平板上不溶血或只呈现α溶血,但在含高盐(7%)的人O型血或兔血以及D-甘露醇做为碳源的我妻氏琼脂平板上可产生β溶血。副溶血性弧菌致病性越强,溶血现象越明显。

图8 神奈川试验现象(左为副溶血性弧菌,右为溶藻弧菌)
(5)培养基的选择及制备注意事项
在《GB4789.10-2016金黄色葡萄球菌检验》标准中,使用的是豆粉琼脂加5%-10%的脱纤维羊血或兔血;在《GB4789.11-2014β型溶血性链球菌检验》标准中,使用的是哥伦比亚血琼脂基础加5%脱纤维绵羊血;在《GB4789.14-2014蜡样芽胞杆菌检验》标准中,使用的是胰酪胨大豆羊血琼脂;在《GB4789.30-2016单增李斯特氏菌检验》标准中,使用的是5%-8%的羊血琼脂。其他文献或标准中也有使用TSA或BHI补加5%-10%脱纤维羊血做成的血琼脂。以上培养基做出来的效果基本一致,本质上都是观察溶血效果,选择哪种培养基并不影响结果观察(注:神奈川试验使用的是单独的我妻氏培养基加入兔红细胞制成的平板,该培养基不能用于其他溶血试验观察)。
注意事项:
1.血液要选用新鲜的无菌脱纤维血,制备如血液出现变色则不能使用。
2.配制培养基时,应预先将血液温育到40-50℃左右,待培养基冷却至50℃左右时加入血液,轻轻摇匀。若血液与培养基温差过大,制成的平板易出现凝块。若摇晃幅度过大,易产生大量气泡,制成的平板不平整。
3.血液对温度比较敏感,加入血液时培养基温度不能过高,加入血液混匀后应立即倒平板,不能长时间保温,否则会导致制成的平板颜色偏深。
4.制成的平板不宜过厚,15mL-20mL为宜,平板过厚不利于观察溶血环。
5.制成的平板应在2-8℃左右低温冷藏,不宜储存过久,若储存过程发现平板变黑或变透明,则不能使用。
注:本文属海博生物原创,未经允许不得载。